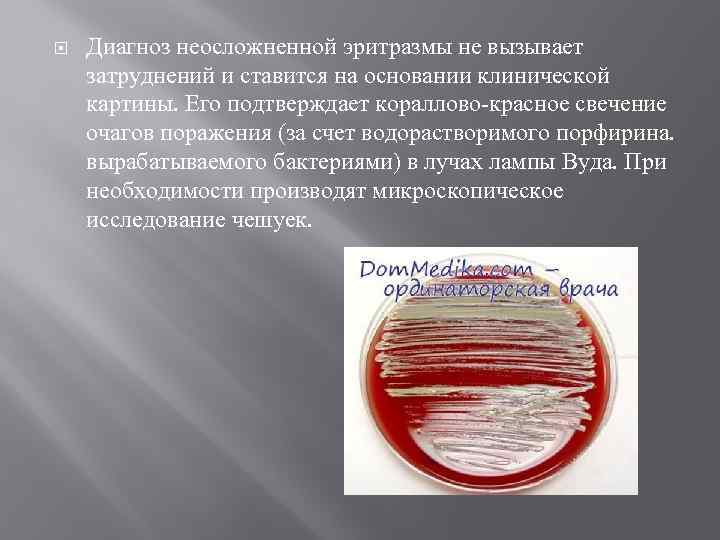

Морфология возбудителей псевдомикозов2222.pptx
- Количество слайдов: 17

МОРФОЛОГИЯ ВОЗБУДИТЕЛЕЙ ПСЕВДОМИКОЗОВ Выполнила: студентка гр. 4 фл Сулагаева А. С. Проверила: Никитина А. Н.

Псевдомикозы включают эритразму и актиномикоз, которые ранее относились к грибковым процессам, но более детальное изучение возбудителей позволило отнести их к особым микроорганизмам, занимающим промежуточное положение между грибами и бактериями.

ЭРИТРАЗМА Эритразма – очень распространенное заболевание кожных складок. Возбудитель эритразмы – Corynebacterium minutissum, ее выявляют в чешуйках эпидермиса в виде тонких слабоветвящихся септированных нитей, между которыми располагаются кокковидные клетки. Развитию заболевания способствует повышенная потливость, несоблюдение правил личной гигиены, а также высокая температура и влажность окружающей среды. Болеют преимущественно мужчины.

Наиболее часто поражаются: ПАХОВО-БЕДРЕННЫЕ СКЛАДКИ ПОДМЫШЕЧНЫЕ ЯМКИ

СОПРИКАСАЮЩИЕСЯ ПОВЕРХНОСТИ ПОД МОЛОЧНЫМИ ЖЕЛЕЗАМИ У ЖЕНЩИН

Вместе с тем очаги эритразмы могут быть на туловище, конечностях (включая межпальцевые складки и своды стоп) и даже на крайней плоти и головке полового члена. У мужчин обычной и весьма характерной локализацией являются участки внутренней поверхности бедер, прилежащие к мошонке (мошонка почти никогда не поражается). В указанных зонах появляются резко отграниченные пятна невоспалительного характера, цвет которых варьирует от желтовато-красного до краснокоричневого. Пятна округлые, размером от точечных до величины монет различного достоинства; при слиянии пятен образуются крупные – до ладони и более – очаги с фестончатыми контурами. Поверхность начальных высыпаний гладкая; со временем присоединяется слабое шелушение мелкими чешуйками. Субъективные ощущения отсутствуют. Под влиянием повышенной влажности, трения и присоединения вторичной инфекции очаги эритразмы в области складок, особенно летом, осложняются воспалительными явлениями (гиперемия, отечность, отторжение рогового слоя) вплоть до формирования опрелости, сопровождающемся зудом.
Диагноз неосложненной эритразмы не вызывает затруднений и ставится на основании клинической картины. Его подтверждает кораллово-красное свечение очагов поражения (за счет водорастворимого порфирина. вырабатываемого бактериями) в лучах лампы Вуда. При необходимости производят микроскопическое исследование чешуек.

АКТИНОМИКОЗ Актиномикоз – хроническое инфекционное неконтагиозное заболевание, поражающее человека и животных, вызываемое актиномицетами. Заболевание наблюдается во всех странах мира. Больные актиномикозом составляют до 10% среди больных хроническими тонными процессами. Мужчины болеют в 2 раза чаще женщин, возраст больных колеблется от 20 до 40 лет.

Актиномикоз поражает органы дыхания, пищеварительный тракт, параректальные ткани, мочеполовые органы, кости, кожу.

Источником инфекции может являться как внешняя среда, так и очаги хронической инфекции в самом организме. Наиболее часто инфекция попадает в организм из внешней среды. Хотя актиномицеты могут с растениями (злаками) попадать на слизистые оболочки (в частности, ротовой полости), они находятся там в форме сапрофитов. Чтобы они превратились в патогенные формы, необходимо развитие воспалительного процесса на слизистых (стоматит, колит, бронхит и другие). При внедрении актиномицетов образуется инфекционная гранулема, которая затем прорастает в окружающие ткани. В центре гранулемы происходят некроз клеток и их распад, возникают абсцессы, которые, прорываясь, образуют свищи. Поражение кожи имеет вторичный характер. В развитии нагноений играет роль и вторичная, преимущественно стафилококковая флора. При благоприятном течении исходом актиномикотической гранулемы является образование фиброзной, а затем плотной рубцовой ткани.

Актиномикоз кожи может быть первичным и вторичным и протекает в виде нескольких форм (узловатая, бугорковая, язвенная и др. ).

Узловатая форма актиномикоза характеризуется образованием плотного, малоподвижного безболезненного узла диаметром 3— 4 см и более, который по мере роста выступает над уровнем кожи и спаивается с ней, отчего кожа приобретает темнокрасный цвет с фиолетовым оттенком. Рядом могут образовываться новые очаги. Узлы склонны к абсцедированию и образованию свищей, через которые изливается гнойное содержимое часто с желтоватыми зернами – друзами актиномицета. Одни свищи рубцуются, другие возникают вновь. Процесс носит упорный хронический многолетний характер и локализуется главным образом в области щечной, подбородочной, поднижнечелюстной областях, в области промежности, межъягодичной складки, ягодиц.

Рис. 1 и 2. Актиномикоз кожи. Рис. 3. Актиномикоз челюстно - лицевой области.

При бугорковой форме, которая обычно развивается при первичном актиномикозе кожи, высыпания представляют собой плотные, полушаровидные темнокрасные бугорки диаметром 0, 5 см, не сливающиеся между собой и вскрывающиеся с выделением капли гноя из образовавшегося свищевого хода и покрывающиеся буро-желтыми корками. Процесс имеет тенденцию поражать подкожную клетчатку и распространяться на соседние топографические области.

Язвенная форма отмечается у ослабленных больных, у которых на месте абсцедировавшпх инфильтратов формируются язвы с мягкими подрытыми неровными краями и вялыми грануляциями на дне.


Морфология возбудителей псевдомикозов2222.pptx